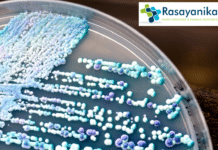
Healthcare Revolution: Plant Compound Defeats Incurable Fungal Infections! Candida

Job Openings at THSTI for Life Science Candidates – Project Associate/ Scientist Post- Attend...
THSTI Jobs for Life Science. Apply Now!
THSTI (Translational Health Science and Technology Institute) is offering exciting career opportunities for life science professionals. We are...
Wastewater’s Hidden Treasure: Bacteria That Generate Electricity
"E. Coli Supercharged: How Tiny Bacteria Are Turning Sewage into Electricity"
E. Coli Supercharged: How Tiny Bacteria Are Turning Sewage into Electricity. In a...
PGIMER Hiring MSc Biotech Candidates – Apply For Tech Assistant Post
PGIMER Hiring MSc BioTech Candidates- Technical Assistant Post!
The Postgraduate Institute of Medical Education and Research (PGIMER) is currently seeking MSc Biotechnology candidates to join...
Ideal Fertility IVF & Genetic Centre Hiring For Molecular Biologist
Latest Molecular Biologist post, Interested and eligible candidates check out all the details given for the same below
Job Position: Molecular Biologist
Job Location: Jabalpur, India
Job...
C-CAMP’s Bold Move to Transform Karnataka’s Health System – Check it out now
C-CAMP's Bold Move to Transform Karnataka's Health System - Check it out now
In a significant development, the Centre for Cellular and Molecular Platforms (C-CAMP),...
Syngene MSc Microbiology/ Biotechnology Executive Role – Apply Online
Syngene MSc Microbiology/ Biotechnology Executive Role - Apply Online. Latest M.sc Candidates at Syngene, Interested and eligible candidates check out all the details given...
Job Opening at Syngene for Life Science Graduates – Apply Now
Job Opening at Syngene for Life science graduates - Masters in life science - Apply Below
Designation : Business Development Lead – Sterile Fill Finish...
IISER TVM Hiring Life Science For JRF Post – Apply Now!
IISER TVM Hiring Life Science For JRF Post - Apply Now!
The Indian Institutes of Science Education and Research (IISER) are currently seeking highly motivated...
Unlocking Alzheimer’s Enigma: The Hidden Role of Brain’s White Matter Revealed
Alzheimer's Enigma Scientists have embarked, In the relentless quest to decode the mysteries of Alzheimer's and related dementia diseases, scientists have embarked on a...
Healthcare Revolution: Plant Compound Defeats Incurable Fungal Infections!
A recent study has uncovered a natural remedy within various plants that effectively inhibits the development of drug-resistant Candida fungi, including the highly dangerous...
Biotecnika Times Newsletter 13.09.2023 Freshers Job Alert, PhD at IICT, Internships + Workshop
Biotecnika Times Newsletter 13.09.2023 Freshers Job Alert, PhD at IICT, Internships + Workshop
FRESHERS Job Alert! MSc Life Sciences, Biotech & Microbiology Project Job at...
Project SRF Position at RCB Faridabad – MSc Life Sciences & Biology Apply
Project-SRF position at Regional Center for Biotechnology - Applications are invited - MSc Life Sciences/Biology graduates - Apply below
Advt. No. 25/Project/2023/HR
Interview for Project-SRF position
Title...
CSIR-IMTECH Project Associate Job – Apply Online
CSIR Project Associate vacancy!
Looking for a rewarding career opportunity in the field of research and development? CSIR (Council of Scientific and Industrial Research) has...
Syngene Hiring MSc Life Science Candidates For Research Associate Post, Apply Online
Latest MSc Job at Syngene. Apply Now!
Syngene, a leading research and development organization in India, is actively seeking MSc Life Science candidates for the...
MSc Biochemistry Job at Syngene – Apply Online
Syngene MSc Biochemistry Job opening. Apply Now!
Syngene, a leading research and development organization in life sciences, is currently offering an exciting opportunity for a...